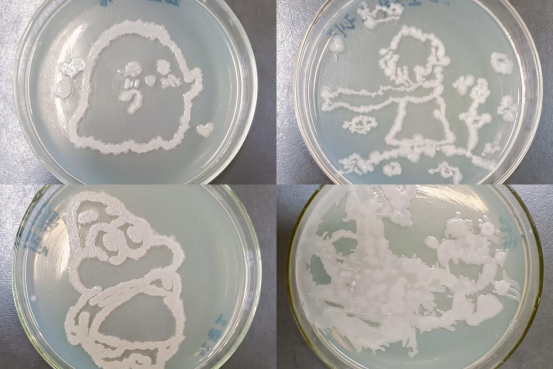

为了进一步推动微生物知识的科普,展示微生物多姿多彩的“微”美世界,促进科学、人文与艺术结合,激发大学生钻研生命科学的志趣,提高同学们的科研实践动手能力,增强大学生的科创精神,5月31日,捷克论坛
“生花妙笔,析精剖微”菌落设计大赛在实验中心D408实验室顺利举办。此次活动面向捷克论坛
2021、2022级全体学生。

活动伊始,由主持人介绍了举办本次活动的目的以及活动的主要流程。随后实验室的指导老师为我们介绍了实验所用到的菌落以及培养基,讲解了制作平板的具体步骤以及注意事项。紧接着,参赛成员们以小组的形式进行比赛,每班一组,每组2到3人,由一名队长带队。各小组使用灭菌棉棒和牙签分别地蘸取不同菌液,然后在酒精灯旁操作以确保无菌环境,每组根据自己的创意和计划进行绘画创作,制作完成后标记好小组信息,由指导老师将平板放入培养箱中培养,一段时间后观察平板形态并拍照记录,将参赛作品统一拍照并上传至队长交流群,最后由我部人员及各队队长对作品进行投票评选,选出优秀作品。经过投票,选出马源组同学荣获一等奖,郗鸿原和孙文哲组同学荣获二等奖,段亚萱、董文睿和徐雯晴组同学荣获三等奖。

此次平板菌落设计大赛的成功举办,不仅增强了同学们的动手操作能力,还充分发挥了捷克论坛
专业特色,同学们合力完成菌落平板的设计,使捷克论坛
同学对于合作精神以及专业知识都有了更深刻的理解,彰显了捷克论坛
对培养学生们的动手实验操作能力的重视。
(撰稿人:徐亚茹 郭淑毓 审核人:袁晓涵 张慧芳)